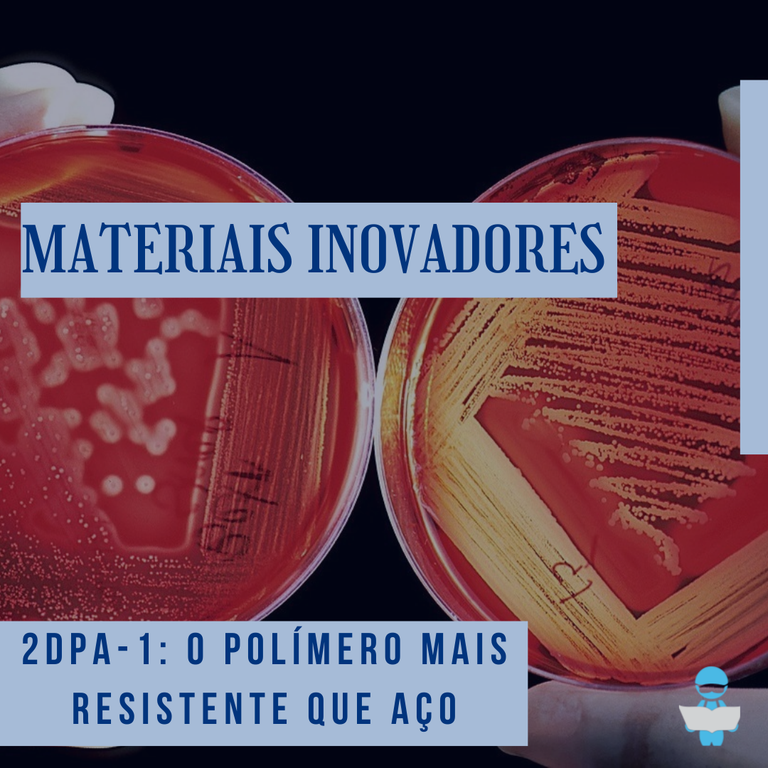

[MATERIAIS INOVADORES]
É contra intuitivo imaginar um polímero ser mais resistente do que aço e ainda assim manter a densidade comum de outros materiais poliméricos, mas uma equipe de engenheiros do Instituto de Tecnologia de Massachusetts (MIT) conseguiu desenvolver um material com esta característica e este foi chamado de 2dpa-1.
O novo polímero criado foi desenvolvido a partir da idealização de uma estrutura 2D, o que é incomum nos materiais poliméricos. Geralmente, quando os monômeros são unidos, é formada uma estrutura 3D, mas a estrutura do 2dpa-1 é plana e isto se deve à matéria-prima utilizada na produção deste novo material. O polímero é formado por monômeros chamados melamina - composto que possui átomos de carbono e hidrogênio - que após alguns processos, são unidos por ligações de hidrogênio, que são ligações fortes.
Devido a essa estrutura, o 2dpa-1 é capaz de ser um material com elevada rigidez e ainda assim ser leve, o que lhe atribui diversas aplicações, como revestimentos de carros atuando como barreira contra impactos ou na construção civil sendo utilizado para estrutura pela sua resistência e baixa densidade.
Fonte:
https://olhardigital.com.br/2022/02/07/ciencia-e-espaco/engenheiros-criam-material-mais-forte-que-o-aco-e-leve-como-o-plastico/
https://samagame.com/03/pt/review-cientistas-criam-material-de-polimero-ultra-resistente/#:~:text=O%202DPA-1%20%C3%A9%20um%20pol%C3%ADmero%202D%20que%20se,de%20cadeias%20de%20blocos%20de%20constru%C3%A7%C3%A3o%20chamados%20mon%C3%B4meros.
https://news.mit.edu/2022/polymer-lightweight-material-2d-0202
t.png)